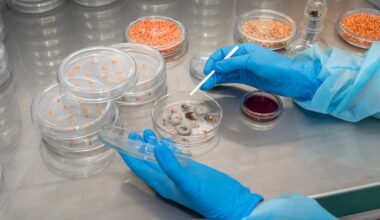

Cadrenal Therapeutics, Inc. (NASDAQ:CVKD) is a clinical-stage biopharmaceutical company focused on addressing critical unmet needs in cardiovascular medicine, particularly in the field of anticoagulation therapies. Founded with the mission of improving outcomes for patients at high risk of thromboembolic events, the company has centered its strategy on developing innovative treatments that go beyond the limitations of existing options like warfarin and direct oral anticoagulants. Headquartered in Florida, Cadrenal is committed to pioneering novel compounds that target patients with complex conditions such as end-stage kidney disease (ESKD), atrial fibrillation, and those reliant on medical devices where the risk of clotting and bleeding complications remain particularly challenging.
The company’s lead asset, tecarfarin, represents a next-generation vitamin K antagonist designed to overcome the drug-drug interaction and metabolic issues that limit the effectiveness of current therapies. Tecarfarin’s mechanism of action is particularly promising for ESKD patients, as its activity remains unaffected by impaired renal function, making it a potential breakthrough therapy in a population where existing anticoagulants fail to provide consistent safety and efficacy. This strategic focus on a highly vulnerable patient population sets Cadrenal apart from many peers and positions it as a potential first-mover in a large, underserved market.
In September 2025, Cadrenal significantly expanded its pipeline through the acquisition of a portfolio of Factor XIa inhibitors from eXIthera Pharmaceuticals. This includes frunexian, a Phase 2-ready intravenous small-molecule inhibitor designed for acute care settings such as cardiac surgery and catheter thrombosis, and EP-7327, an oral Factor XIa inhibitor intended for chronic thrombotic conditions. The move into Factor XIa inhibition highlights Cadrenal’s forward-looking approach, as epidemiological evidence supports the idea that Factor XIa is essential for thrombosis but not required for normal hemostasis, making it an attractive and differentiated target for safer anticoagulation. With both acute and chronic applications now in its portfolio, Cadrenal is diversifying its development pipeline and expanding its potential to capture value across multiple high-risk patient populations.
The company’s long-term growth is anchored not only in its innovative science but also in its strategic market approach. By focusing on conditions with few effective options, such as anticoagulation for dialysis-dependent patients, Cadrenal has identified opportunities that offer both clinical relevance and commercial potential. Additionally, orphan drug designation for tecarfarin in left ventricular assist device patients underscores the regulatory advantages and market exclusivity that the company can leverage. Combined with a lean operating structure and a relatively low share count, Cadrenal’s focused pipeline creates an asymmetric risk-reward profile that makes it a compelling player in the small-cap biotech space.
Acquisition of Factor XIa Inhibitors Unlocks New Opportunities
A major bullish development came on September 15, 2025, when Cadrenal announced the acquisition of a portfolio of Factor XIa inhibitors from eXIthera Pharmaceuticals. This deal added significant depth to Cadrenal’s pipeline and diversified its risk profile. Central to this acquisition is frunexian, a Phase 2-ready small molecule Factor XIa inhibitor intended for intravenous administration in acute settings such as cardiopulmonary bypass and catheter thrombosis. Unlike conventional FXa or thrombin inhibitors, frunexian targets Factor XIa, which plays a central role in thrombosis but is less critical for normal hemostasis. This unique mechanism suggests a therapeutic window that could reduce clotting risk without the bleeding complications often seen with traditional anticoagulants.
What makes frunexian stand out is its acute care focus, making it one of the only agents in development specifically designed for high-risk settings such as complex cardiac surgeries. Early Phase 1 trials already demonstrated strong tolerability and rapid clearance, an important advantage for critical care scenarios where clinicians must balance anticoagulation with surgical safety. The acquisition also brought EP-7327, an oral Factor XIa inhibitor with potential in chronic thrombotic conditions, giving Cadrenal both acute and chronic therapeutic angles in the rapidly growing anticoagulation market.

CHECK THIS OUT: Tiziana (TLSA) Surges 143% in 2025 and Immuneering (IMRX) Reports 86% 9-Month Survival in Pancreatic Cancer.
Tecarfarin: A Differentiated Oral Anticoagulant for High-Risk Populations
While the Factor XIa inhibitors provide new opportunities, Cadrenal’s lead asset remains tecarfarin, a novel vitamin K antagonist (VKA) that differentiates itself from warfarin and direct oral anticoagulants (DOACs). Tecarfarin’s metabolism avoids the cytochrome P450 pathway, reducing drug-drug interactions and providing more stable dosing—a critical factor for patients with comorbidities or impaired kidney function.
The company’s strategy is laser-focused on patients with end-stage kidney disease (ESKD) transitioning to dialysis, a population where anticoagulation therapy remains highly controversial and where both warfarin and DOACs present significant challenges. Clinical data suggest current options either fail to reduce cardiovascular risk or expose patients to higher bleeding complications. Tecarfarin, by contrast, maintains activity in ESKD patients and has the potential to fill this glaring unmet need. Cadrenal has already announced plans for a pivotal clinical trial in this indication, with enrollment expected in the first quarter of 2026 and topline data anticipated within a year.
A successful outcome in this trial would not only validate tecarfarin’s safety and efficacy in ESKD patients but also provide a platform for label expansion into other high-risk groups such as patients with left ventricular assist devices (LVADs), where anticoagulation is critical but current standards of care remain suboptimal.
Strong Clinical Rationale for Factor XIa Targeting
The rationale behind Factor XIa inhibition is another bullish factor. Patients with congenital Factor XI deficiency are known to have lower rates of venous thromboembolism (VTE) and ischemic stroke without exhibiting spontaneous bleeding tendencies. Epidemiological data confirm that elevated FXI levels correlate with increased clotting risks, reinforcing the therapeutic value of inhibition. This makes FXIa inhibition a unique target: it can reduce thrombosis risk while minimizing bleeding complications, addressing one of the longest-standing tradeoffs in anticoagulant therapy.
Cadrenal’s move into this space not only positions it alongside major pharmaceutical players pursuing FXIa inhibitors but also gives it a differentiated asset in frunexian with acute-care applications where other competitors have not yet focused. This angle could prove pivotal if clinical results show superior safety and effectiveness compared to standard agents.
Financial Position and Market Valuation
On August 11, 2025, Cadrenal reported its second quarter financials, showing no revenues as expected for a pre-commercial biotech. R&D expenses were $1.1 million versus $1.3 million in the same quarter last year, while G&A expenses increased to $2.7 million, reflecting higher public company costs and stock-based compensation. As of June 30, 2025, the company held approximately $5.6 million in cash and equivalents.
Although the current cash balance is sufficient to fund operations into mid-2026, additional capital will be required to advance both tecarfarin and frunexian through pivotal trials. With just 2.0 million shares outstanding and 3.1 million on a fully diluted basis, Cadrenal maintains an exceptionally low float compared to peers. This tight structure magnifies both risk and reward: successful trial results could drive significant upside given the small number of shares in circulation, while financing needs may introduce dilution in the near term.
Notably, Zacks Small Cap Research continues to model Cadrenal with a valuation target of $30 per share, reinforcing that the market may be undervaluing its pipeline potential relative to its current price levels.
Strategic Outlook and Growth Potential
Cadrenal’s long-term growth prospects rest on three pillars: advancing tecarfarin in high-risk populations, accelerating the development of frunexian and other Factor XIa inhibitors, and leveraging orphan drug designations and regulatory incentives to secure exclusivity and reduce development risks. If tecarfarin’s trial in dialysis patients proves successful, it could establish Cadrenal as the leader in anticoagulation for a population where current options are dangerously inadequate. Meanwhile, frunexian’s progress could provide a second growth engine with applications in both acute and chronic thrombotic conditions.
With cardiovascular disease remaining the leading cause of mortality worldwide and anticoagulation therapy being a multi-billion-dollar global market, even niche success in these segments could translate into significant revenue streams for Cadrenal. The company’s small size and low float further amplify the bullish thesis: positive clinical milestones or strategic partnerships could catalyze outsized stock performance relative to its current valuation.
Conclusion
Cadrenal Therapeutics has rapidly evolved from a single-asset developer into a broader anticoagulant innovator with multiple shots on goal. The acquisition of frunexian and its FXIa inhibitor portfolio strengthens its pipeline, while tecarfarin continues to progress toward pivotal testing in one of the highest unmet-need populations in cardiovascular care. Financially, the company’s lean structure and low share count set the stage for significant upside if clinical results validate its approach. While risks remain high as with any development-stage biotech, the potential rewards make Cadrenal a compelling speculative play for investors seeking exposure to the future of anticoagulant therapy.
READ ALSO: CEL-SCI (CVM) Stock Could Explode After Saudi Breakthrough Deal and Ondas Holdings (ONDS) Lands $2.7M Defense Order.